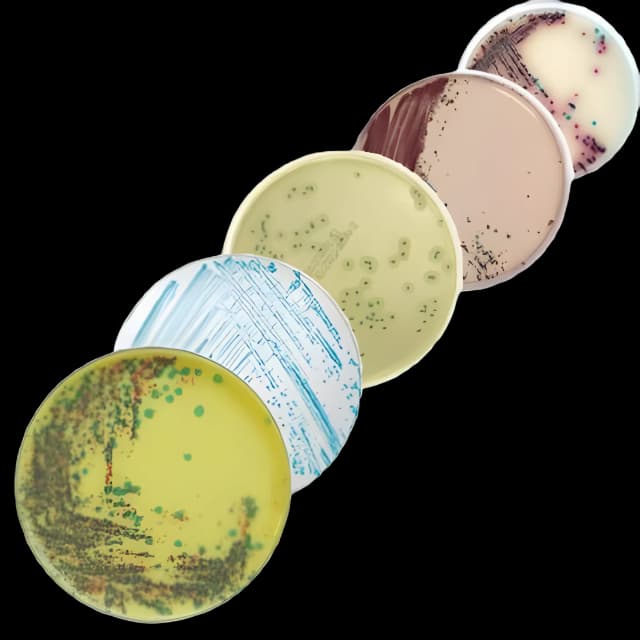
chromID® Chromogenic Media for C. difficile - Biomerieux 43871

chromID® Chromogenic Media Mono-Plate for Clostridium difficile Screening - 43871
USAMP#95646465SKU: 43871chromID®

Product Spotlight
- Specifically designed chromogenic media for efficient screening and isolation of Clostridium difficile.
- Produces easy-to-interpret gray to black colonies against a clear agar background, simplifying identification.
- Accelerates diagnostic processes with a rapid 24-hour incubation period, significantly faster than the traditional 48-72 hours required by other methods.